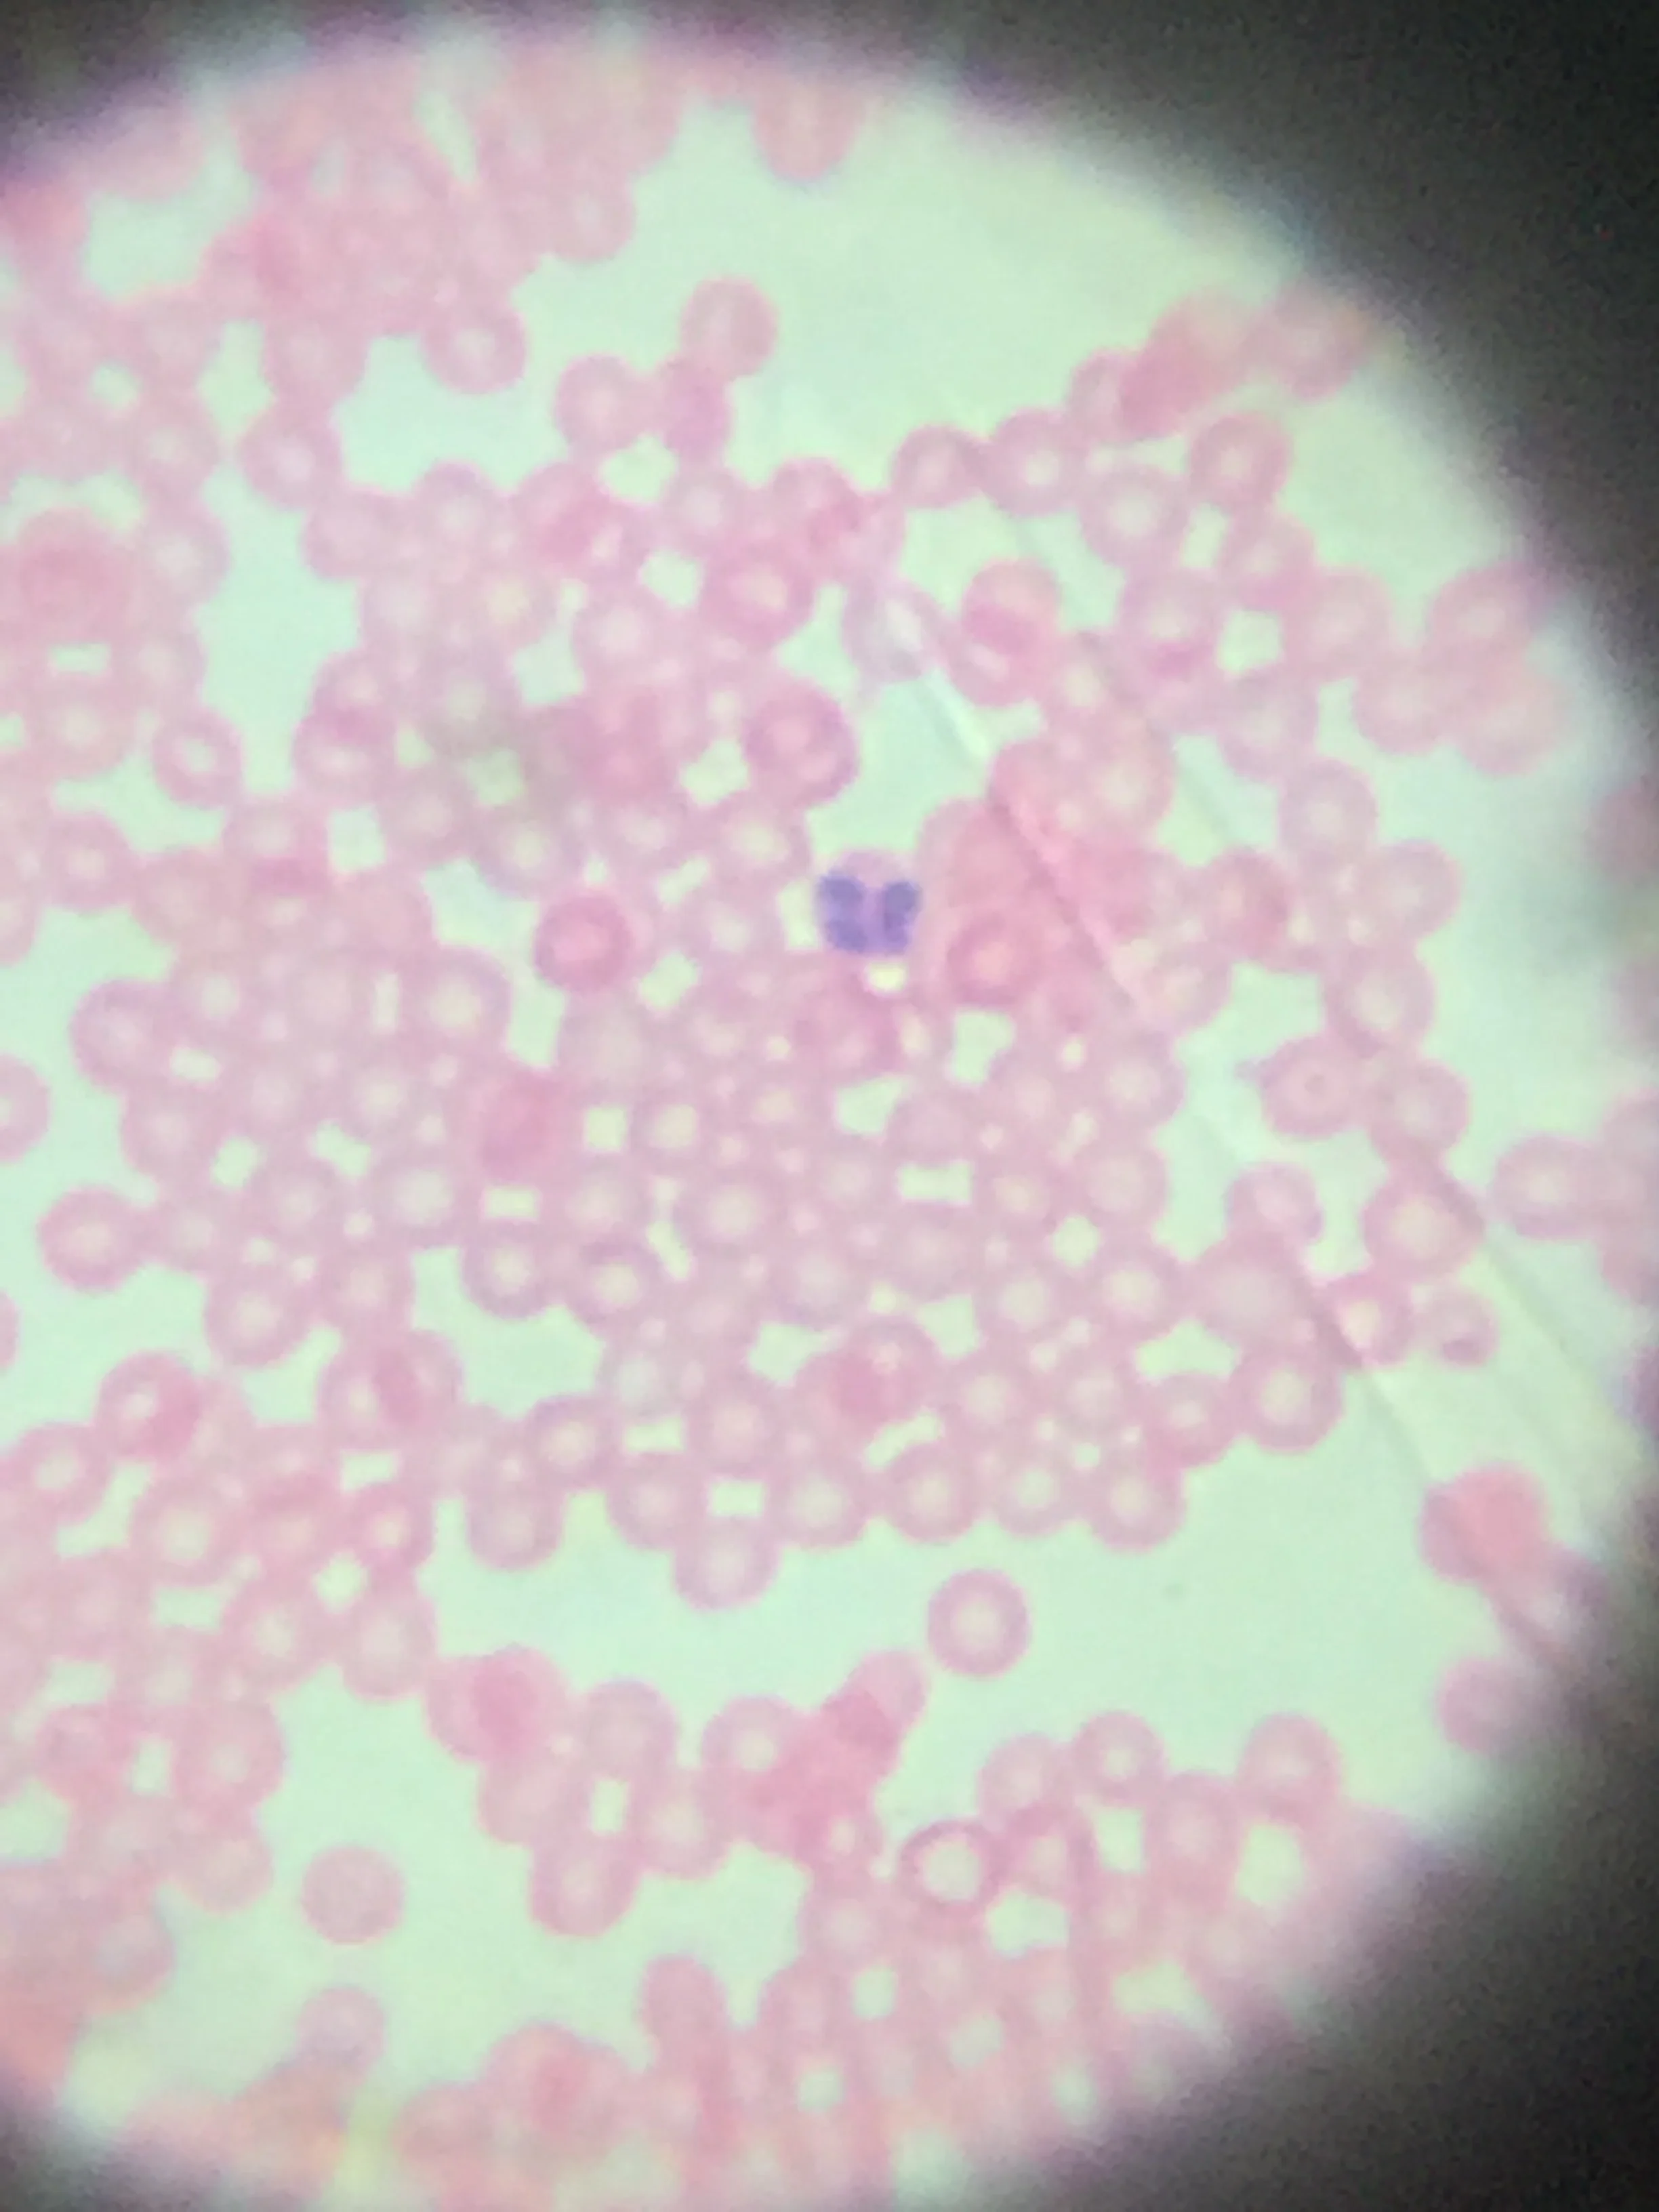

Startup: Catalyst Frame Microscope Part3 - Marketing and Public Relations
Do people want this and why would they choose this over other available products?
Now at this point I've already established that there was a demand for smartphone microscopes from multiple successful Kickstarters that have raised thousands of dollars. They were all fantastic products, but my microscope did solve pain points in those products albeit with it's own weakness.
Micro Phone Lens 150x: Cell Phone Based Microscope - Raised $111,645
Requires constant manual pressure in order to keep a focused image
Pressure makes it difficult to use with cover slips that can slip around
Only one level of magnification
The MicrobeScope - Raised $119,988
Only one level of magnification
Requires a unique case for each device
Sample is placed directly on the lens
Requires a standard microscope which is expensive and large/heavy
mibo : A Full Featured Microscope Kit For Your Phone - Raised $7,160
Large device
Limited magnification
My microscope worked relatively similar to a regular microscope with multiple levels of magnification, adjustable stage, and you could easily position+re-position the slide you're looking at. Overall, what was important here is there's demand and that it occupied its own point in the market space.
Now what I needed to do was convey everything that this microscope could do and see, and I needed stunning visuals to convey that message. Everything I've looked at thus far has been only static prepared microscope slides, which were amazing, but only showed a fraction of it's capability.
So I hopped out to Home Depot, drilled some holes into a bucket, ran some rope through it, and went to the pier in Pacifica to collect some sea water samples. (Side note: While I was at Home Depot, someone saw me with the bucket and rope and mentioned how he used to use that to collect sea water to look at under the microscope!) But anyways this is what I caught:
Then I wanted to show off what happens when there's a combination of a microscope, camera, and software. So I wanted to take multiple pictures and have then stitched together to make a 'gigapixel' image. Most of the image-stitching apps just did panoramics, but I eventually found an app that let you stitch images together in any orientation. Amazingly enough the distortion on the edge of the image from the ball lenses didn't impact performance too much.
Finally to get a time-lapse, I bought an onion, peeled off a thin membrane layer, and stained it with some HE (hematoxylin and eosin) stain I got. Then I added some salt to the slide, letting it dissolve and wick under the cover slip onto the onion tissue while recording.
That covers most the visual assets.
Specifications
But then there's everything you say, and anything you say is a promise that you'll deliver said thing. So if you want to say it, you better make sure you're right. If you overpromise and underdeliver, a good product can still look like crap.
Of course you need to say something, you can't just say it has great magnification. And since this is a smartphone/tablet microscope, I need to figure out the magnification, resolution, compatibility, and a price.
Magnification Spec
So for magnification, I had a laser focusing lens used for the low mag, a compound lens using two laser focusing lenses, and a ball lens for the high mag. But what's the actual magnification? One may think well just take a picture of something and see how much bigger it is than the actual object. The good ole equation from physics Magnification = Image_height/Object_height. But that doesn't work, it'll change depending on the screen size. We need to go with something that'll give us the magnification based off something more concrete and easily accessible such as the dimensions of the lens itself.
Now trying to measure the dimensions of the laser focusing lens would be ridiculously hard to do precisely, the answer was to use the simple ball lens with a known index of refraction and radius. I went and looked up some ball lenses equations and put together this little python script.
n = 1.517 #index of refraction
r = 1 #radius of ball lens in mm
#magnification of lens
mag = 250/((n*r)/(2*(n-1)))
#back focal length - distance from lens surface to sample
bfl = (.5)*(r*(2-n))/(n-1)
print( "Mag= " + str(mag))
print( "BFL= " + str(bfl))
It turns out the magnification of the 2mm sapphire ball lens was roughly 170x. Then I took pictures of a micro-ruler and measured the pixel width. I took the largest width possible without distortion at the highest magnification to make sure I got the best measurement possible. And then with the relative pixel widths and knowing the ball lens magnification I back-calculated the magnification for the other two.
In addition, the back focal length was only 0.467mm. A coverslip is generally about 0.17mm thick. So with a ~0.3mm gap between the lens and the top of the coverslip for a focused image, this microscope had to be built in mass with extremely precise movements.
Resolution Spec
Resolution is specifically the gap distance between two features without them blurring together. Unfortunately sometimes you run calculations and what you get doesn't make any sense, which was basically what happened to me. So we turn to measurement! Luckily this is fairly straightforward, you just look at progressively smaller features until it no longer becomes visible.
E. coli, approximately 1.1-1.5 microns in width by 2-6 microns in length
Human red blood cells and a multi-lobed leukocyte, approximately 8 microns in width
Conservatively the resolution was said to be 5 microns.
Smartphone / Tablet Compatibility
At this point I've tested it with a few devices my iPhone, a friends Samsung, and HTC. I believed it was pretty much universally compatible. But that assumption needs to be validated more rigorously, imagine if you shipped it all around the world, and it turns out X-brand phone don't work for some reason. So I went to a local Fry's and tried it out on a bunch of different smartphones and tablets. And that's where I learned that some devices (especially cheaper tablets) don't have auto-focus+auto-exposure for the camera and then made it a requirement in the copy.
Wrap-Up
The price will be covered in the following manufacturing section.
Now a lot of you might say this isn't what marketing is all about, a lot of it is about understanding your customer. Although now I know that marketing involves a lot more than driving demand for your product, it's also a lot about figuring out who is your market for this product. The same product can look like crap to one person while it may look like an authentic Mona Lisa for $100 to another. And at the end of the day, it's really hard to build something that's appealing to everyone in terms of price, quality, and features in a market generally filled with competitors of some kind. So in order to be successful, you need to focus on building your product around some target segment. And the things you could learn through this focus are incredibly important. For instance, is your customer sensitive or insensitive to changes in price. There should be some marketing before developing the product.
And then once you understand that segment, you need to figure out how to develop some marketing plan/apparatus to find them, get them in the door, and get them to share it in some way shape or form. Because whether it's a good product or not if people don't like it, don't recommend it, stops using it, no one sees it, and they forget about it, you won't that get viral growth. Instead, you'll constantly be trying to push a product into the market rather than it being pulled into the market.
This was definitely where I was slacking, because what I had to deal with next was..... Manufacturing.
Next: Catalyst Frame Microscope Part 4: Manufacturing... There Be Dragons